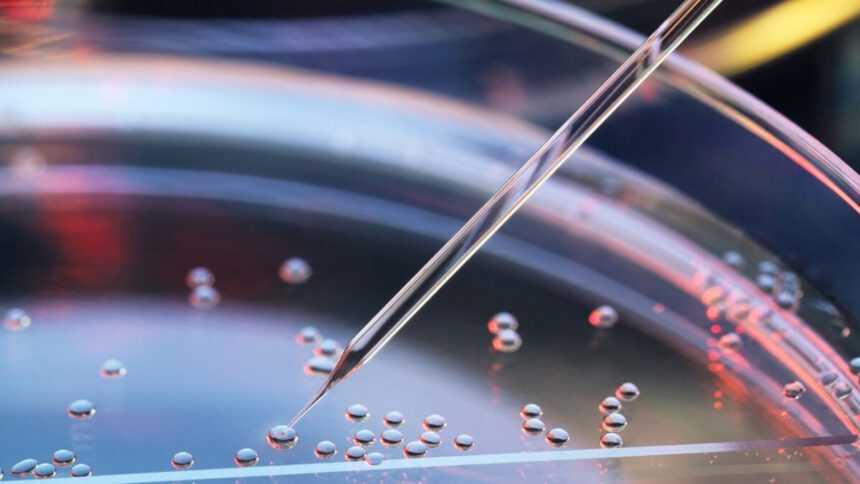
Un cerotto fatto di staminali contro l’insufficienza cardiaca 1

È pronto il cerotto fatto di cellule staminali che può trattare forme di insufficienza cardiaca avanzata, una delle principali cause di morte nel mondo.
La sua sperimentazione è avvenuta con successo su primati e su un unico paziente umano, e ora la sua efficacia e la sua affidabilità saranno ulteriormente testate in un trial clinico appena approvato.
La potenziale scoperta si deve al gruppo di ricerca guidato dal Centro tedesco per la ricerca cardiovascolare (Dzhk) e dal Centro medico universitario di Gottinga, il risultato è stato poi reso pubblico attraverso la rivista Nature.
Come funziona il cerotto fatto di staminali

Il cerotto fatto di staminali è un muscolo cardiaco coltivato in laboratorio ed è composto da cellule cardiache derivate da cellule staminali indotte.
Questa tecnologia, sperimentata per circa 3-6 mesi nel trattamento di macachi rhesus effetti da patologia e successivamente su un paziente umano con grave insufficienza cardiaca, avrebbe fornito risultati sufficienti affinché si possano far partire i test clinici del caso.
Le diverse terapie che abbiamo per l’insufficienza cardiaca risultano essere molto poche, oltre che poco accessibili per via della scarsa disponibilità di organi per i trapianti e l’alto costo dei dispositivi artificiali.
Un’alternativa è rappresentata dall’impianto di cellule muscolari cardiache per sostituire quelle danneggiate, ma si tratta di una procedura troppo rischiosa e poco efficiente.
Per avere un’alternativa valida e superare i diversi problemi, i ricercatori sono partiti da cellule staminali capaci di generare qualsiasi tessuto corporeo, e le hanno fatte differenziare in cellule del muscolo cardiaco.
È stato ottenuto così il cerotto, con un tessuto pressoché identico a quello del muscolo cardiaco. In tutti i casi sperimentati, i risultati hanno mostrato un miglioramento della funzionalità del cuore senza evidenziare effetti collaterali dannosi.
La sfida era generare e impiantare un numero sufficiente di cellule muscolari cardiache da cellule staminali pluripotenti indotte dai macachi rehsus per favorire la riparazione cardiaca senza effetti collaterali come l’aritmia cardiaca o un tumore.
Ha puntualizzato, soddisfatto, Wolfram-Hubertus Zimmermann, direttore del Dipartimento di farmacologia e tossicologia della University Medical Center e direttore scientifico degli studi preclinici e clinici sul cerotto cardiaco.
La simulazione effettuata sul cerotto fatto di cellule staminali è stata di fondamentale importanza per raccogliere i primi risultati sullo studio. Ora ulteriori test clinici testeranno ulteriormente la sicurezza di tale trattamento.
Leggi anche: Malattie cardiovascolari, fattori di rischio e come difendersi